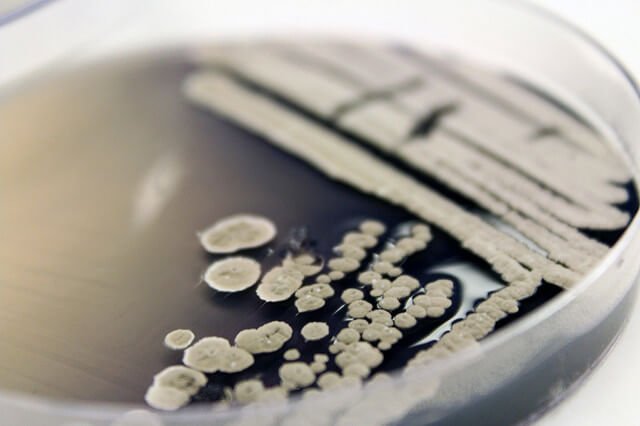
Як вибрати бактерії для септиків і вигрібних ям

Хто такі редуценты і чому вони нам допоможуть? Як працюють корисні бактерії для септиків і вигрібних ям? Від чого залежить ефективність і як розбудити бактерії? Які бактерії купити і реальні відгуки покупців.

Я вже писав про те, як вибрати найкращий септик для дому та дачі. Сьогодні розповім які купувати бактерії для септиків і вигрібних ям не бояться хімії
Природа нам допоможе
Природа давно придумала спосіб утилізації мертвої органіки. Рано чи пізно все, що колись було живим, переходить в неорганічну форму, накопичується у вигляді мінералів, повертається в середу вуглекислим газом і водою.
Займаються такою утилізацією організми під назвою «редуценты», до яких відносяться майже всі гриби і деякі види бактерій. Ці організми пристосовані до життя в будь-якому середовищі — в рідкій, повітряної, кисневої та навіть анаеробної.

Так що септики і вигрібні ями таким бактеріям вже точно «по зубах».
Як працюють корисні бактерії
У сприятливих умовах бактерії чудово справляються зі своєю роботою і швидко розкладають трупи тварин, екскременти і опале частини рослин в грунт або неорганічні речовини. Причому, швидкість розмноження і розкладання в певних умовах буває дуже високою.
На кухні вже давно використовуються дріжджові гриби, бактерії молочнокислого і спиртового бродіння. Кінцевим продуктом їхньої діяльності є оцет і спирт. З цієї групи кухонних трудівників в септик можна було б запускати дріжджові гриби і бактерії, що виробляють спирт.
Однак спиртові бактерії дуже примхливі і їм потрібно багато вуглеводів, а дріжджові гриби можуть породити дуже швидкий процес.Так що для керованого процесу утилізації вмісту септиків і вигрібні ями необхідно купувати особливі бактерії.

Проблема ускладнюється ще й там, що в стоках зазвичай міститься багато миючих засобів, які пригнічують діяльність живих організмів.
Від чого залежить ефективність бактерій
Бактерії — це живі істоти, які адаптовані до певних умов середовища. Їх активність залежить від:
- температури;
- наявності різких перепадів температури;
- наявності світла;
- кількості кисню;
- концентрації ксенобіотиків (речовини, чужі для живих організмів).
Для септиків і вигрібних ям необхідні бактерії, здатні працювати в будь-яких умовах — аеробних, анаеробних, з агресивними середовищами з лужною або кислою реакцією. Для вигрібних ям, не мають каналізаційного стоку, підійдуть мікроорганізми, чутливі до побутової хімії. Якщо в септик зливаються всі стоки з дому, то потрібні мікроорганізми, з великою стійкістю до лугів.
Проте всі бактерії повинні бути адаптовані до умов повної темряви, не бояться хімії та постійно отримувати тепло без різких перепадів.
Як розбудити бактерії
Незважаючи на десятки варіантів, всі бактерії в упаковках перебувають в анабіозі. У такому вигляді поміщати їх в септик не можна — можуть і не прокинутися.
Для того, щоб їх розбудити, потрібно попередньо розвести препарат у певній кількості теплої води. Кількість води зазвичай зазначено в інструкції по застосуванню. Іноді потрібно додати органіки, наприклад, цукру.
Явною ознакою початку активної життєдіяльності бактерій є піднімаються бульбашки повітря. Це вуглекислий газ — продукт розпаду органіки. Після цього вода з бактеріями виливається в септик.
Рідкі засоби можуть також розлучатися водою або одразу виливатися в септик. Але в будь-якому випадку рідина якийсь час потрібно потримати в теплі, щоб переконатися, що бактерії живі.
Посудину з просыпающимися бактеріями не можна поміщати на яскраве світло, а особливо на пряме сонячне.
Які бактерії купувати
Найбільш поширеними є бактерії для септика не бояться хімії. До них відносять:
Доктор Робік
Використовується як для септиків, так і для вигрібних ям. Містить в собі 109 видів мікроорганізмів у стані спір. З цієї причини володіє універсальністю — може розкладати органіку в різних станах: папір, целюлозу, крохмаль, жири, білки.
Біо-септ
Використовується як універсальний засіб для септиків і вигрібних ям. Забезпечує розкладання жирів, ПАР, екскрементів. Особливість полягає в здатності розріджувати донні кірки і осад, знижуючи ймовірність засмічення. Запускати бактерій потрібно часто — бажано тричі в місяць. Хлорорганічні речовини пригнічують діяльність бактерій.
Біоактиватор «Зелена сосна»
Застосовується для вуличних туалетів та вигрібних ям. Крім бактерій, в склад входять ензими, органічні носії і ароматизатор з хвойним ароматом. . Добре розкладає жири і екскременти, знижує можливість розмноження мух. Бактерії здатні переробляти вміст септика практично до стану добрива.
Відгуки
Ось які відгуки про бактеріях для септиків і вигрібних ям мені вдалося знайти в інтернеті:
Анастасія, 38 років, Самара р.
«У мене септик на три блоки. Поставили недавно, ось підбираємо бактерій, з’ясовуємо які краще. Найбільше ефекту отримали від бактерій в препараті „Доктор Робік“. Мало того, що вони добре справляються, адже їм ще не заважають всякі домішки у вигляді миючих засобів.
В інструкції було сказано, що один пакетик розрахований на 1500 літрів. Однак виробники приємно обдурили — насправді цього пакетика вистачає на 3000 літрів. Результат відчувається швидко. Підсипаємо „Доктор Робік“ приблизно раз на 30-50 днів і поки скаржитися нема на що.»
Павло, 30 років, Ленінградська область
«Чесно скажу — не пам’ятаю, що всипав у свою вигрібну яму. Купив щось розрекламоване, висипав весь пакет. Спочатку нічого. У тому сенсі, що ніякого ефекту. А потім почалося як в анекдоті про дріжджі в сортирі. Запаху вистачило не тільки на наш ділянку, але й сусідам дісталося. Мабуть бактерії повільно гойдалися, так швидко працювали.»
Олександр, 40 років, Вологда
«Мене якось зацікавило засіб „Байкал“. Насипав у першу секцію бетонного септика. Начебто все добре, але потім на дні утворився спресований твердий осад, але який не вимивається. Я так вважаю, що це добре — з органіки вийшла неорганіка, але сипати, напевно, потрібно було у другій септик. І ще — цей „Байкал“ дійсно усуває запах.»
Євген Іванович, 53 роки, Новосибірськ
«Хочу поділитися досвідом. Використав французький препарат BIAZIM (Цесклин). У нас він з’явився недавно, вирішив випробувати імпортних бактерій. Осад значно зменшився, запах пропав через добу. Поки що експеримент вдався. Збираюся продовжити.»
